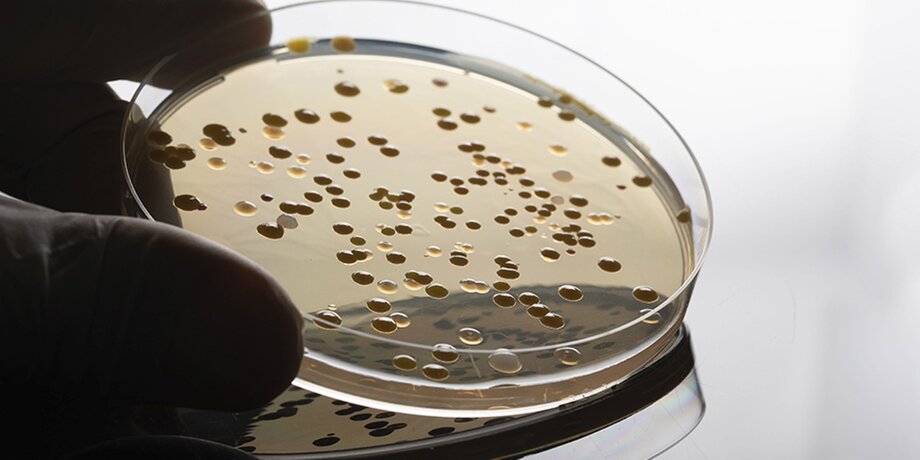

После зимы климатическую технику необходимо правильно подготовить к новому сезону, предупредили эксперты. Как это сделать и чем могут быть опасны загрязненные кондиционеры, разбиралась Москва 24.
Не стоит ждать жару
Механизм действий по подготовке к сезону одинаков как для сплит-системы, так и для обычного кондиционера. Об этом Москве 24 рассказал специалист по обслуживанию климатической техники Владислав Баннов.
В техническом плане разница между ними в том, что у сплит-системы может быть несколько внутренних блоков для охлаждения, размещенных в разных частях квартиры, а у кондиционера он подразумевается один.
Эксперт уточнил, что вызывать специалиста лучше с того момента, когда на улице установилась плюсовая погода: в этот период еще нет ажиотажа и можно договориться с мастером на удобное время.
Баннов также пояснил, что если устройство используется только на охлаждение и зимой не включается, профилактическую чистку стоит проводить раз в год в конце марта или начале апреля. Если же прибор работает и зимой, рекомендуется проводить вторую чистку в сентябре-октябре.
"Обслуживание в полном объеме в среднем по Москве стоит около 5 500 рублей. Вызов альпиниста, если внешний блок находится в труднодоступном месте, – от 15 000 рублей в зависимости от этажа и сложности, но в большинстве квартир мастер может добраться до внешнего блока через окно без специального снаряжения", – рассказал специалист.
Эксперт отметил, что самостоятельно владелец техники может только очистить фильтры. Они представляют собой сетки, которые можно снять и промыть обычной водой без использования моющих средств. Для этого нужно открыть внутренний блок: производители обычно предусматривают легкий доступ.
А вот фреон, по мнению специалиста, менять каждый сезон не нужно: о необходимости сигнализирует либо ухудшение охлаждения, либо обледенение прибора. Для профилактики стоит делать замену раз в 3–5 лет.
Стоимость заправки зависит от объема. На домашнем устройстве обычно требуется 600–700 граммов фреона. Цены у разных поставщиков варьируются от 500 рублей за 100 граммов, а комплексная работа (слив старого фреона, вакуумирование системы и заправка нового по весам) может обойтись примерно в 7 000 рублей, заключил Баннов.
Опасно для здоровья
В свою очередь, заслуженный врач России Андрей Осипов в разговоре с Москвой 24 подчеркнул, что несвоевременная чистка кондиционера может стать серьезным источником опасности для здоровья. Особую угрозу представляют бактерии, скапливающиеся в фильтрующих элементах.
По словам специалиста, возможно также и грибковое поражение легких, которое схоже по симптомам с легионеллезом. Для него характерны кашель, часто с мокротой, одышка, лихорадка, слабость, боль в груди, потеря аппетита и головная боль.
"Чтобы поставить точный диагноз, необходимо сделать рентген и провести лабораторные исследования. Эти заболевания протекают крайне тяжело, особенно у пожилых, пациентов со сниженным иммунитетом и тех, у кого есть хронические заболевания: бронхоэктатическая болезнь, хроническая обструктивная болезнь легких", – отметил он.
Осипов подчеркнул, что при неправильном использовании кондиционера существует и риск переохлаждения: когда пользователи устанавливают слишком низкую температуру, возникает резкая смена температурного режима, что приводит к спазму сосудов.
"Это опасно для пациентов с сердечно-сосудистыми патологиями, так как спазм может привести к нарушениям кровообращения вплоть до инсульта. Кроме того, сухой холодный воздух вызывает изменения кожных покровов, аллергические реакции, а спазм сосудов – головные боли", – уточнил эксперт.
Для защиты семьи врач рекомендовал соблюдать несколько простых мер. Во-первых, своевременно чистить домашние и автомобильные кондиционеры – минимум раз в год, когда начинается сезон использования. Во-вторых, поддерживать комфортную температуру в помещении: нормальной считается 22–24 градуса. Плюс не следует направлять поток холодного воздуха на кровать.
 Сергей Собянин вручил награды выдающимся работникам культуры Москвы
Сергей Собянин вручил награды выдающимся работникам культуры Москвы